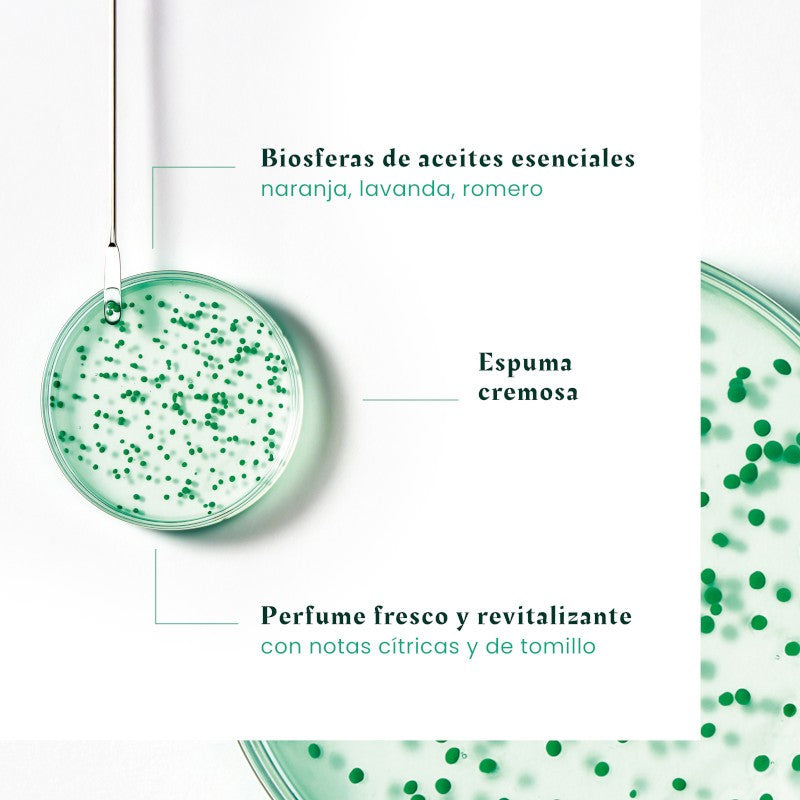

-
-13%
-
-13%
-
-13%
-
-13%
-
-13%
-
-13%
-
-13%
-
-13%
-
-13%
-
-13%
-
-13%
-
-13%
RENE FURTERER Forticea Duplo Energizing Shampoo 2x200ml (2nd Unit at 40%)
Regular price
€24,31
Sale price
€24,31
Regular price
€27,99
Unit price
/
per
This product adds 2–3 days to the delivery time.
- 100% natural Fortifying Energizing Shampoo.
- Suitable for all hair types.
- Indicated for Damaged Hair, Without Shine and Lack of Vitality.
- Strengthens Hair from the Root.
- It stimulates hair growth.
- Stronger, healthier and more vigorous hair.
- With Guarana Extract and Orange, Lavender and Rosemary essential oil.
Couldn't load pickup availability

RENE FURTERER Forticea Duplo Energizing Shampoo 2x200ml (2nd Unit at 40%)
RENE FURTERER Forticea Duplo Energizing Shampoo 2x200ml (2nd Unit at 40%)
€24,31
€27,99
More from Rene Furterer for you. Discover products you’ll love:
-
-9%Vendor:
RENE FURTERER Triphasic Progressive 8 Bottles
Regular price €71,01Sale price €71,01 Regular priceUnit price / per€78,11Sale -
-12%Vendor:
RENE FURTERER Vitalfan Progressive Anti-Hair Loss 60 Capsules + 30 FREE
Regular price €41,40Sale price €41,40 Regular priceUnit price / per€47,41Sale -
-9%Vendor:
RENE FURTERER Triphasic Reactional Anti-Hair Loss Treatment 12 Ampoules
Regular price €48,98Sale price €48,98 Regular priceUnit price / per€54,20Sale -
-31%Vendor:
RENE FURTERER Forticea Energizing Shampoo 200ml
Regular price €11,58Sale price €11,58 Regular priceUnit price / per€16,90Sale -
-14%Vendor:
RENE FURTERER Protective Sun Oil Kpf 50⁺ 100 ml
Regular price €11,53Sale price €11,53 Regular priceUnit price / per€13,56Sale -
-9%Vendor:
RENE FURTERER Naturia Invisible Dry Shampoo 75 ml
Regular price €6,22Sale price €6,22 Regular priceUnit price / per€6,84Sale -
-11%Vendor:
RENE FURTERER Vitalfan Reactional Anti-Hair Loss 60 Capsules + 30 FREE
Regular price €40,89Sale price €40,89 Regular priceUnit price / per€46,10Sale -
-39%Vendor:
RENE FURTERER Naturia Gentle Micellar Shampoo 400 ml
Regular price €12,15Sale price €12,15 Regular priceUnit price / per€20,02Sale -
-27%Vendor:
RENE FURTERER Triphasic Stimulating Anti-Hair Loss Shampoo 200 ml
Regular price €11,52Sale price €11,52 Regular priceUnit price / per€15,99Sale -
-15%Vendor:
RENE FURTERER Protective Sun Fluid Kpf 50⁺ 100 ml
Regular price €15,27Sale price €15,27 Regular priceUnit price / per€17,97Sale
More details
Explore more. These essentials may also be of interest to you:
-
-36%Vendor:
EUCERIN Sun Gel-Creme Oil Control Dry Touch SPF 50+ (50ml)
Regular price €15,04Sale price €15,04 Regular priceUnit price / per€23,71Sale -
-0%Vendor:
DEXERYL Emollient Cream 500 ml
Regular price €13,67Sale price €13,67 Regular priceUnit price / per€13,75Sale -
-24%Vendor:
Gema Herrerías 0.3 RETINOL-NP Serum 30 ml
Regular price €28,00Sale price €28,00 Regular priceUnit price / per€36,90Sale -
-26%Vendor:
Gema Herrerías Cremagel Barrier Function Intensive Treatment 50 ml
Regular price €29,41Sale price €29,41 Regular priceUnit price / per€40,10Sale -
Vendor:
ISDIN Fusion Water Magic SPF 50 (50ml)
Regular price €27,90Sale price €27,90 Regular priceUnit price / per€26,95 -
-26%Vendor:
RILASTIL Aqua Intense 72h Gel-Cream 40ml
Regular price €12,53Sale price €12,53 Regular priceUnit price / per€16,99Sale -
-1%Vendor:
HELIOCARE Oral 90 Capsules
Regular price €27,64Sale price €27,64 Regular priceUnit price / per€27,99Sale -
-20%Vendor:
LA ROCHE POSAY Cicaplast Baume B5+ (100ml)
Regular price €14,89Sale price €14,89 Regular priceUnit price / per€18,69Sale -
-20%Vendor:
LIPIKAR Baume AP+M Emollient Balm 400ml - LA ROCHE POSAY
Regular price €17,23Sale price €17,23 Regular priceUnit price / per€21,70Sale -
-27%Vendor:
Gema Herrerías 5 AZELAIC-S Daily Exfoliating Lotion 150ml
Regular price €23,79Sale price €23,79 Regular priceUnit price / per€32,90Sale